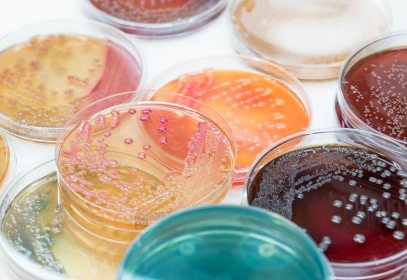
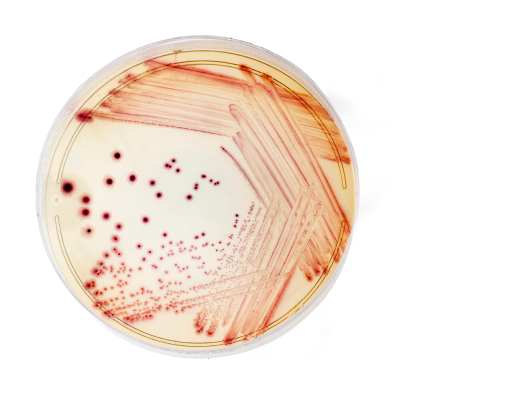
A petri dish with red lines and dots from a food pathogen.
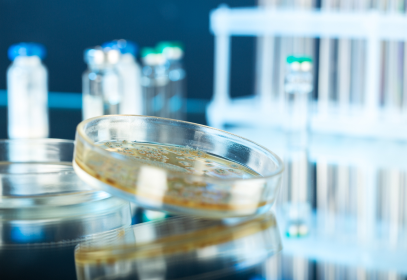
Yellow petri dish on a laboratory table.

Free Food Safety Training Videos & Downloads
Choose a topic to view free food safety training videos & downloads
Select a topic below to watch our free food safety training videos, download free food safety system resources, or become a client and access a package of employee food safety training videos, quizzes, and training logs that are not publicly available – at no additional cost in both English and Spanish.